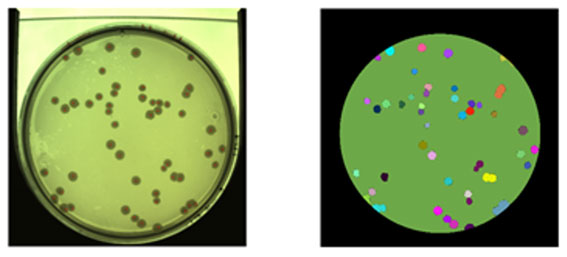

Suscríbete a nuestra newsletter

Máquinas que aprenden por sí solas. De esto va la rama de la inteligencia artificial conocida como “Machine Learning”. En AINIA ya estamos aplicándola a sistemas de control de calidad y seguridad alimentaria, desde el control de placas Petri en laboratorios de análisis de alimentos, al análisis de datos para optimizar procesos productivos en la industria. En el artículo damos las claves.
La complejidad de los productos y los procesos de fabricación de la industria alimentaria, así como el volumen y disparidad de datos que se generan, obligan a avanzar de forma decidida en la aplicación de técnicas de aprendizaje automático (“Machine Learning”) para extraer información que ayude a la toma de decisiones.
Este tipo de técnicas permite clasificar las ingentes cantidades de información de datos en tiempo real y, por lo tanto, utilizar al máximo el potencial de la industria 4.0. Si entrenamos a las máquinas para que, al igual que los sistemas neuronales, resuelvan problemas complejos como la detección de defectos o la identificación de patrones en tiempo real, las potencialidades del procesamiento digital de imágenes son inmensas.
Estas técnicas requieren de una gran potencia de cálculo para procesar la gran cantidad de datos mediante algoritmos que permiten la paralelización. El Machine Learning utiliza la alta capacidad de cálculo de las GPU (Unidades de Procesamiento Gráfico) permitiendo realizar el análisis en tiempo real. El gráfico anterior (Fuente NVIDIA) representa el incremento de velocidad al emplear en el procesado una GPU.
El procesamiento digital de imágenes es una disciplina que integra diversas áreas de conocimiento como son la informática, la electrónica y la física. Esta disciplina permite el análisis y procesamiento de imágenes digitales mediante el uso de ordenadores, con el fin de extraer información útil de las mismas para llevar a cabo alguna tarea en particular. En nuestro caso, la aplicamos al control de calidad y la seguridad alimentaria en línea, en diferentes sectores de producción (frutos secos y snacks, productos hortofrutícolas, carnes, vinos…)
Nuestra experiencia nos permite afirmar que el procesamiento digital de imágenes es un área de gran importancia en la industria, ya que ayuda:
En AINIA llevamos décadas desarrollando aplicativos en este campo y ahora hemos dado un paso más incorporando técnicas de Machine Learning al procesamiento digital de imágenes, con unos resultados realmente sorprendentes.
El uso de técnicas de Machine Learning en la lectura automática de placas Petri en los laboratorios de control de alimentos de AINIA está permitiendo, en un trabajo de I+D propia, obtener una tasa de acierto global del 95% frente al 68 por ciento obtenido utilizando técnicas convencionales de reconocimiento de patrones.
En la imagen pueden ver los resultados obtenidos en recuento tradicional de placas, con un acierto de 46/53 colonias detectadas, mientras que la misma muestra procesada utilizando machine learning obtuvo una tasa de acierto de 53/53.
La detección de objetos en tiempo real es otro de los campos de aplicación de esta destacada disciplina de la inteligencia artificial. Google ya lo está haciendo, por ejemplo, en la clasificación y distinción de diferentes materiales y objetos en tiempo real y con alta precisión utilizando la lectura de aprendizaje automático de bases de datos complejas alimentadas a través de ondas electromagnéticas que dejan una huella única.
El diagnóstico de enfermedades a partir de imágenes médicas es otro campo de aplicación donde ya hay experiencias demostrables. Un ejemplo son las pruebas de autodiagnóstico realizadas por la Universidad de Harvard.
En la industria alimentaria estas técnicas son muy útiles para el control de calidad, un claro ejemplo de esto es la aplicación de técnicas de maching learning para evaluar la calidad interna de la fruta, para predecir la calidad del vino o para clasificar productos cárnicos.
En AINIA estamos especializados en el desarrollo de tecnologías aplicadas a la Industria 4.0 en el campo de la alimentación y la salud. Si considera que podemos cooperar con Ud. para conseguir que la inteligencia artificial pueda ayudarle a optimizar sus procesos y mejorar su aportación de valor al mercado y al consumidor final, llámenos, estaremos encantados de contarle lo que hemos hecho y cómo le podemos ayudar.


| Responsable | AINIA |
| Domicilio | Calle Benjamín Franklin, 5 a 11, CP 46980 Paterna (Valencia) |
| Finalidad | Atender, registrar y contactarle para resolver la solicitud que nos realice mediante este formulario de contacto |
| Legitimación | Sus datos serán tratados solo con su consentimiento, al marcar la casilla mostrada en este formulario |
| Destinatarios | Sus datos no serán cedidos a terceros |
| Derechos | Tiene derecho a solicitarnos acceder a sus datos, corregirlos o eliminarlos, también puede solicitarnos limitar su tratamiento, oponerse a ello y a la portabilidad de sus datos, dirigiéndose a nuestra dirección postal o a privacy@ainia.es |
| Más info | Dispone de más información en nuestra Política de Privacidad |
| DPD | Si tiene dudas sobre como trataremos sus datos o quiere trasladar alguna sugerencia o queja, contacte al Delegado de protección de datos en info@businessadapter.es o en el Formulario de atención al interesado |
Consiento el uso de mis datos personales para que atiendan mi solicitud, según lo establecido en su Política de Privacidad
Consiento el uso de mis datos para recibir información y comunicaciones comerciales de su entidad.